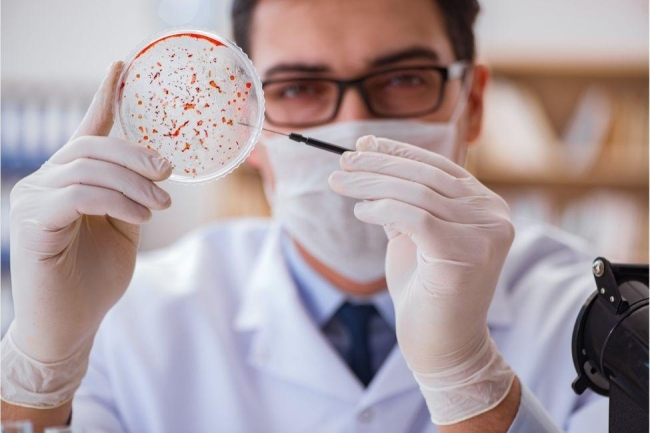

Бактеріологічне дослідження, яке ще називається бакпосівом (https://rcld.com.ua/analizi/bakteriologichni/), варто робити, якщо лікар підозрює наявність бактеріальної інфекції. В такому випадку здається аналіз для визначення конкретного збудника хвороби.
Також можна одразу визначити чутливість виявленого збудника до антибіотиків (це називається антибіотикограмою).
Дана опція є дуже корисною в сучасних умовах, коли багато бактеріальних агентів мутують і набувають антибіотикорезистентності, що ускладнює лікування.
Сімейна лабораторія (https://rcld.com.ua/) пропонує пройти бактеріологічне дослідження у Харкові, Ужгороді та інших містах України.
Що таке бакпосів?
Бакпосів – це дослідження біологічного матеріалу (крові, мокротиння, калу, сечі, відокремлюваного з носа, зіва, ока, вуха, рани, дихальних шляхів і статевих органів, а також таких специфічних матеріалів, як ліквор (спинномозкова рідина), жовчі тощо.
Тобто, по суті, будь-який матеріал з організму, який можна розмістити на поживних середовищах в чашках Петрі і культивувати за певних комфортних для розмноження бактерій температур.
Зазвичай бакпосів – це тривалий процес, що займає від 5 до 10 днів, за які відбувається поступове наростання колонії бактерій. Лаборанти щодня оцінюють наявність бактерій в зразку і швидкість їх розмноження.
Якщо необхідно дослідити чутливість бактерії до препаратів, під час дослідження в зразок додаються препарати і відстежується реакція бактеріальної колонії на них.
Особливості дослідження
Важливо пам’ятати, що мікробіом людини (сукупність всіх бактерій, що є в організмі) досить різноманітний, і не всі бактерії та гриби, що входять до складу мікрофлори є корисними. Існує велика кількість бактерій, які входять до “умовних патогенів”, тобто, перебувають в організмі в малих кількостях, не розмножуючись і не викликаючи жодних симптомів. Однак в стресових для організму умовах (вагітність, зниження імунітету, анемія, розвиток системних захворювань, виснаження тощо) може початися стрімке розмноження бактерій, що призведе до розвитку захворювань.
Тому дуже часто важливим є не сам факт виявлення тих чи інших бактерій, а їхня концентрація в досліджуваних зразках.
Правила підготовки до здачі аналізу напряму залежать від виду досліджуваного матеріалу.
Головною вимогою є проведення дослідження до початку антибіотикотерапії або через мінімум 2 тижні після її закінчення.
Детальну інформацію про дослідження можна отримати в адміністраторів Сімейної лабораторії.